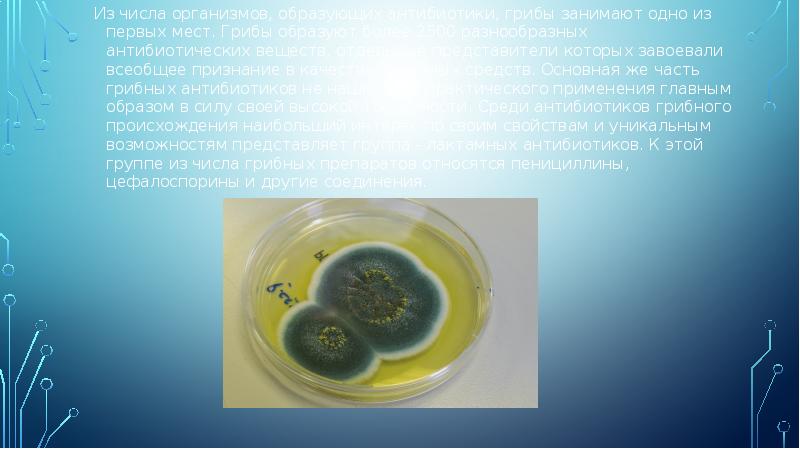
Из числа организмов, образующих антибиотики, грибы занимают одно из первых мест. Из числа организмов, образующих антибиотики, грибы занимают одно из первых мест.

Производство вакцин, антибиотиков и медицинских препаратов презентация
Содержание
- 2. Лекарственное средство– любое вещество или продукт, используемые, чтобы модифицировать или исследовать
- 3. Антибиотики В настоящее время под антибиотиками понимают химиотерапевтические вещества, полученные из
- 4. Термин «антибиотик» был предложен в 1942 г. С. А. Ваксманом для
- 5. Антибиотики представляют собой самую многочисленную группу лекарственных средств. Они используются для
- 6. Антибиотики находят применение в сельском хозяйстве, прежде всего как лечебные препараты
- 7. Некоторые из антибиотиков с успехом применяются в пищевой и консервной промышленности
- 10. В современных условиях производства принимают меры к максимальному снижению себестоимости препаратов
- 11. Из числа организмов, образующих антибиотики, грибы занимают одно из первых мест.
- 12. Пенициллин-самый первый в мире антибиотик. В 1871 г. В .А.
- 13. Выдающееся открытие русских ученых не получило широкой известности, и в 1928
- 14. Для практических целей медицины пенициллин получают в промышленности путем биосинтеза. Процесс
- 15. Антибиотики из бактерий в химическом отношении более однородны и в подавляющем
- 16. К антибиотическим веществам животного происхождения относят: К антибиотическим веществам животного происхождения
- 17. Антибиотики растительного происхождения (называют фитонцидами)-комплексы соединений, выделяемые растениями – эфирные масла,
- 18. Вакцины Вакцины - препараты, получаемые из микроорганизмов или продуктов их жизнедеятельности;
- 19. Первооткрывателем вакцин считают английского ученого Эдварда Дженнера (1749–1823)-вакцина от оспы.
- 20. Производство любой вакцины начинают с получения антигена — именно той чужеродной части, на проникновение
- 21. Эти бактерии и вирусы достаточно опасны, поэтому подлежат дальнейшей обработке и очистке. Во время
- 22. После очистки в полученный препарат добавляют консерванты и стабилизаторы, чтобы вакцина длительное время
- 23. В конце производственного процесса готовые вакцины фасуют во флаконы или шприцы и запечатывают для
- 24. Каждое государство, по рекомендациям ВОЗ, имеет национальный орган контроля, который проверяет соблюдение
- 25. Основные этапы контроля: Основные этапы контроля: испытания новых вакцин разработчиком и организацией
- 26. Сыворотки Иммунные сыворотки – это иммунобиологические препараты, приготовленные из сыворотки крови
- 27. Метод лечения кровяными сыворотками (серотерапию) разработали в конце XIX века Эмиль Адольф
- 28. Сывороточные препараты используют в следующих целях: Сывороточные препараты используют в
- 29. Для получения антитоксических сывороток животных вначале иммунизируют анатоксином, а после создания
- 30. Сыворотки можно получать также из культивируемых на искусственной питательной среде животных
- 31. Значение иммунобиологических препаратов сложно переоценить. Применение сывороток для профилактики и лечения
- 32. Таблетки Таблетка – это строго дозированное лекарство в заданной твердой форме.
- 33. ПРЕССОВАНИЕ ПРЕССОВАНИЕ После растворения и взвешивания материалов, входящих в состав будущих
- 34. СУХОЕ ГРАНУЛИРОВАНИЕ СУХОЕ ГРАНУЛИРОВАНИЕ Порошки перемешиваются между собой в нужных количествах,
- 35. ВЛАЖНОЕ ГРАНУЛИРОВАНИЕ ВЛАЖНОЕ ГРАНУЛИРОВАНИЕ Смысл существования такой технологии в том, чтобы
- 36. Оборудование при фармацевтическом производстве применяется в зависимости от выбранного метода изготовления
- 37. Далее, в зависимости от выбранного метода, могут использоваться: Далее, в зависимости
- 38. Фармацевтические заводы построены по цеховому принципу, обычно они имеют 4 основных
- 39. Витамины Среди биологически активных веществ, необходимых для нормального развития организма животных,
- 40. Открытие витаминов принадлежит поляку Казимиру Функу . В 1911г ученый выделил
- 41. Производство витаминов осуществляется следующими основными путями: Производство витаминов осуществляется следующими основными
- 42. Витамин В1 защищает нервную систему от истощения и переутомления, способствует превращению
- 43. Витамин C (аскорбиновая кислота) помогает заживлению ран, усиливает рост, вырабатывает устойчивость против
- 44. Сиропы и микстуры Одновременно с твердыми лекарственными формами широкое распространение
- 45. Сиропы - это концентрированные водные растворы сахарозы, которые могут содержать лекарственные
- 46. В настоящее время различают несколько методов приготовления сиропов: В настоящее время
- 47. Технология приготовления алтейного сиропа: 4 части измельченного корня настаивают (мацерация) в
- 48. Применяется сироп в разных отраслях. К наиболее востребованным относятся: Применяется сироп
- 49. Спасибо за внимание
- 50. Скачать презентацию

Слайды и текст этой презентации
Скачать презентацию на тему Производство вакцин, антибиотиков и медицинских препаратов можно ниже:
Похожие презентации





























